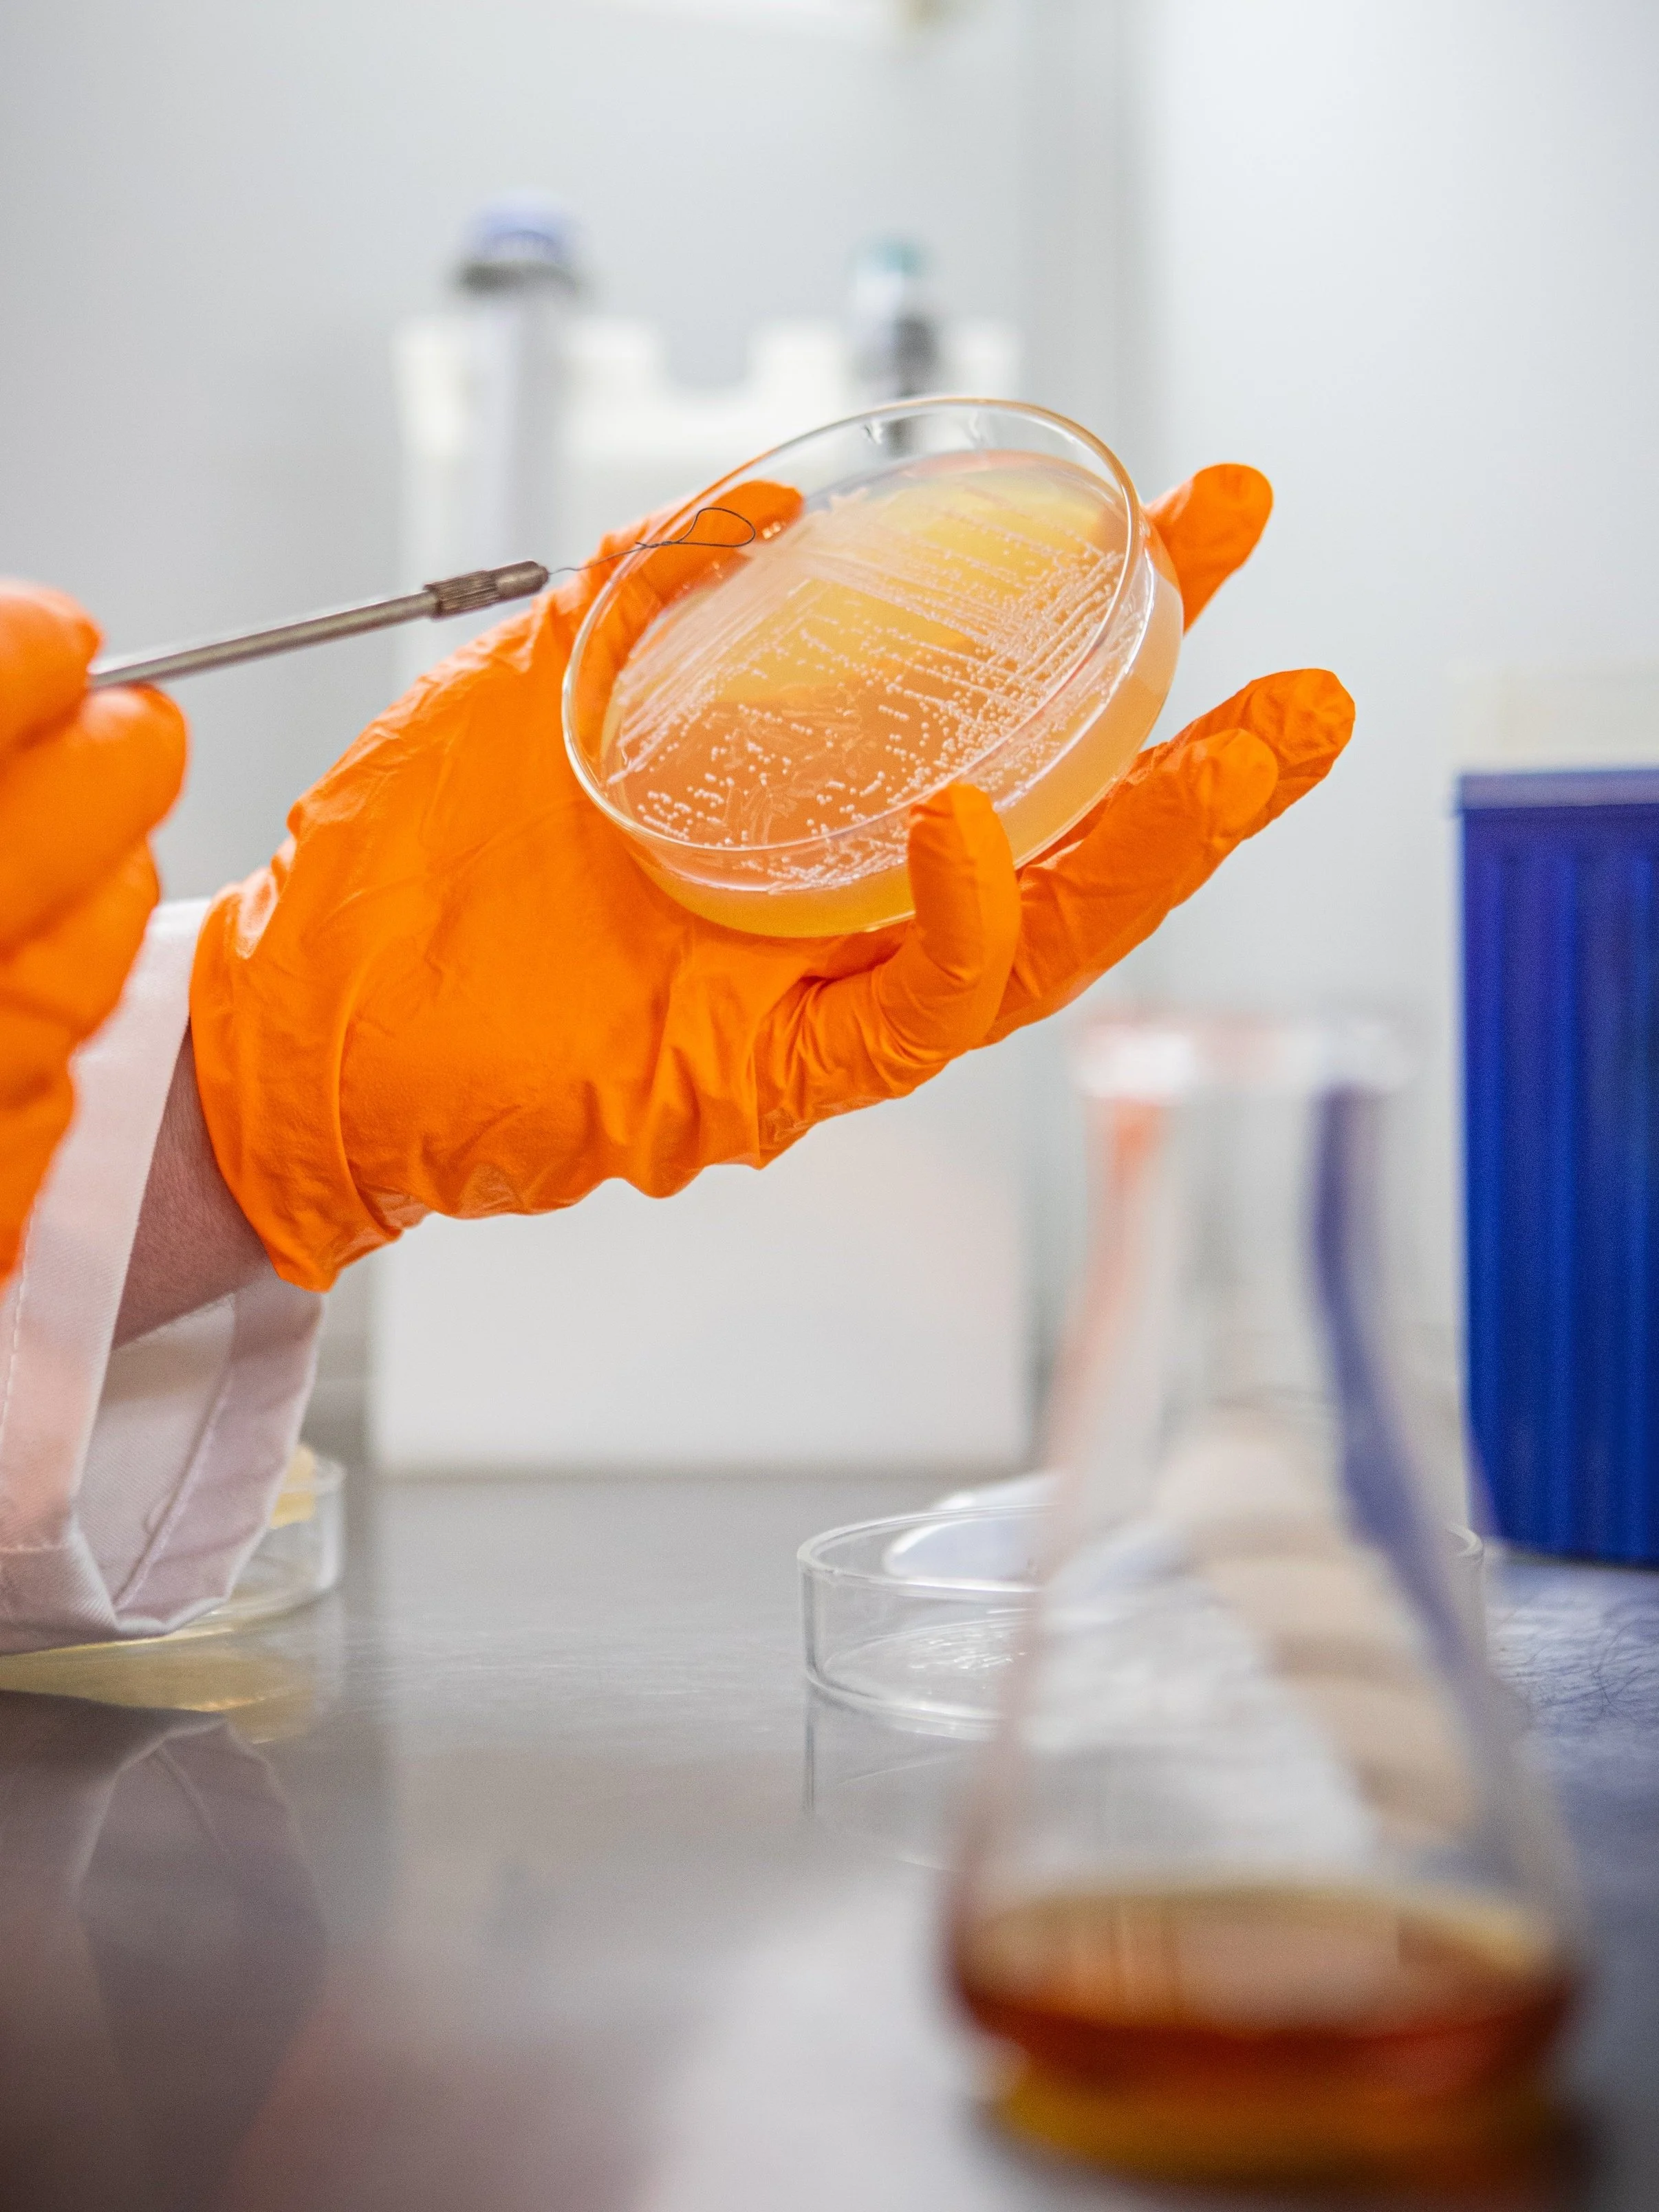

TASTE NATURE. DRINK SCIENCE.
Pure yeast cultures built for breweries across NZ and Australia. It’s the yeast we can do.
WHAT THE FROTH?
Aotearoa NZ is internationally renowned for its ability to produce top quality brews, and the ingredients that make them. Our hops are world famous, our barley is of the highest quality, and our water is sought around the world for its freshness and purity.
Back in 2018 Simon Cooke & Ryan Carville took a leap of faith, to craft a more local offering and grow fresh liquid yeast cultures right here in NZ. And with that, Froth Technologies was born.
Today, we are one of the most trusted sources for quality yeast in the South Pacific. From custom propagations, through to bulk dry yeast, and fermentation nutrition. We help you brew the best beer.
NZ MADE YEAST
Our liquid yeasts are lovingly grown from our bank of frozen cultures, along a custom developed propagation pathway that optimises yeast health, and ensures purity and high cell density.
Froth Technologies raises traditional brewing strains that brewers love, and we are developing new and novel strains to give our brewers a leading edge. Now supplying over 80+ breweries around Australia & NZ, our yeast quality & performance is proven through award-winning beers from the most sought-after craft breweries.
FRESH NEWS
Healthy fermentations don't happen by accident.
Modern wort often comes up short on key nutrients, especially in high-adjunct beers, hazy styles, low grav wort, and during repeated yeast re-pitching. When yeast run out of what they need, they start scavenging, stressing, and cutting corners. That is when you see stalled ferments, off-flavours, poor haze stability, and inconsistent results.
Our new & improved formulation, Yeast Mode Plus is a yeast-derived all-in-one nutrient designed to support a wide range of fermentation needs.
AWARD WINNING
-

MORTON COUTTS 2019
The Morton Coutts Trophy is a prestigious award designed to recognise outstanding innovation and/or achievement in the brewing industry of New Zealand.
-

WELLINGTON GOLD AWARDS FINALIST
The Wellington Gold Awards celebrate excellence and enterprise of businesses in the Wellington Region.
-

BUSINESS INNOVATION AWARD 2021
The Food Awards quality mark remains the peak of excellence in New Zealand’s food and beverage industry.